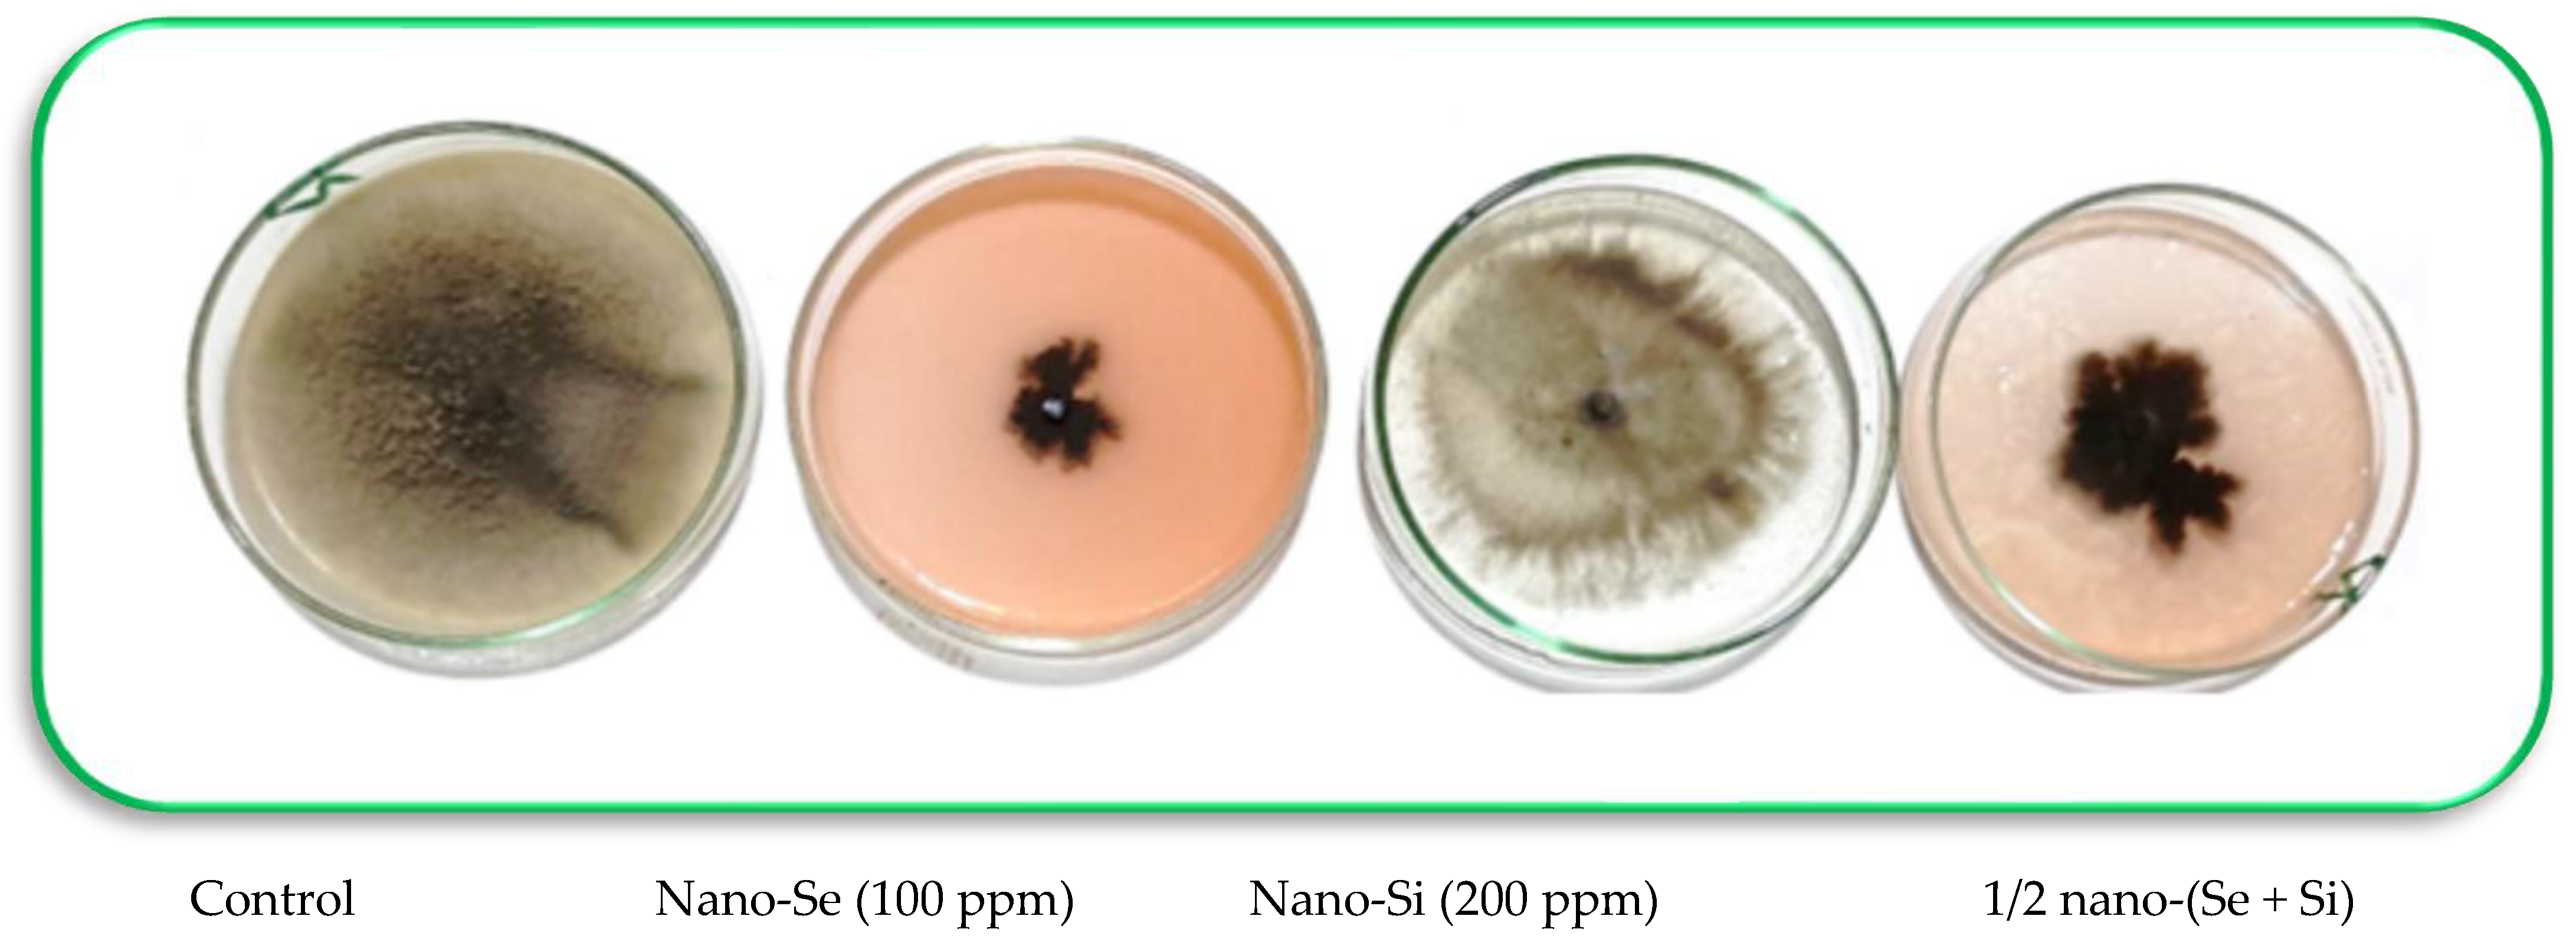
Microorganisms 11 00728 g003 Microorganisms 11 00728 g003

Nanofungicides with Selenium and Silicon Can Boost the Growth and Yield of Common Bean (Phaseolus vulgaris L.) and Control Alternaria Leaf Spot Disease
Abstract
1. Introduction
2. Materials and Methods
2.1. Pathogen Isolation, Purification, and Pathogenicity Tests
2.2. Preparing Nanoparticles
2.3. In Vitro Experiments
2.4. Field Experiments
2.5. Vegetative Growth Traits, Yield and Photosynthetic Attributes
2.6. Antioxidant Enzymes, Antioxidative Activity and Electrolyte Leakage
2.7. Microscopic Examination
2.8. Statistical Analyses
3. Results
3.1. Pathogenicity Tests
3.2. In Vitro Antifungal Activity of Nano-Se and Nano-SiO2
3.3. Microscopic Investigation
3.4. Disease Severity and Efficacy Percent under Field Conditions
3.5. Vegetative Growth and Photosynthetic Traits
3.6. Enzymatic Activities
3.7. Antioxidant Activity and Electrolyte Leakage
3.8. Response of Total Yield of Dry Seeds to Applied Nanoparticles
4. Discussion
5. Conclusions
Author Contributions
Funding
Institutional Review Board Statement
Informed Consent Statement
Data Availability Statement
Acknowledgments
Conflicts of Interest
References
- Félix-Pablos, C.M.; Parra-Cota, F.I.; Santoyo, G.; Orozco-Mosqueda, M.C.; Santos-Villalobos, S.D. Draft genome sequence of Bacillus sp. strain FSQ1, a biological control agent against white mold in common bean (Phaseolus vulgaris L.). Curr. Res. Microb. Sci. 2022, 3, 100138. [Google Scholar] [CrossRef] [PubMed]
- FAOSTAT. Tomato Production in 2019, Crops/Regions/World List/Production Quantity (Pick Lists); Corporate Statistical Database (FAOSTAT); UN Food and Agriculture Organization: Rome, Italy, 2020. [Google Scholar]
- Mukankusi, C.; Raatz, B.; Nkalubo, S.; Berhanu, F.; Binagwa, P.; Kilango, M.; Williams, M.; Enid, K.; Chirwa, R.; Beebe, S. Genomics, genetics and breeding of common bean in Africa: A review of tropical legume project. Plant Breed. 2019, 138, 401–414. [Google Scholar] [CrossRef] [PubMed]
- El-Dahshouri, M.F.; Hamouda, H.A.; Anany, T.G. Improving seed production of common bean (Phaseolus vulgaris L.) plants as a response for Calcium and Boron. Agric. Eng. Int. CIGR J. 2017, 2017, 211–219. [Google Scholar]
- Girma, F.; Fininsa, C.; Terefe, H.; Amsalu, B. Evaluation of common bean (Phaseolus vulgaris) genotypes for resistance to common bacterial blight and angular leaf spot diseases, and agronomic performances. Heliyon 2022, 8, e10425. [Google Scholar] [CrossRef] [PubMed]
- Rahmanzadeh, A.; Khahani, B.S.; Taghavi, M.; Khojasteh, M.; Osdaghi, E. Genome-wide meta-QTL analyses provide novel insight into disease resistance repertoires in common bean. BMC Genom. 2022, 23, 680. [Google Scholar] [CrossRef] [PubMed]
- Adomako, J.S.; Yeboah, J.F.; Asamoah, P.; Amankwaa-Yeboah, E.A.; Adjei, E.A.; Obeng, B.; Sakyiamah, M.; Lamptey, L.; Asibuo, B.J.Y. Survey of plant parasitic nematodes and disease severity of common bean lines evaluated for reaction to root knot nematodes infestation. Afric. Crop. Sci. J. 2022, 30, 147–154. [Google Scholar] [CrossRef]
- Rady, M.M.; Elrys, A.S.; Selem, E.; Mohsen, A.A.A.; Arnaout, S.M.A.I.; El-Sappah, A.H.; El-Tarabily, K.A.; Desoky, E.M. Spirulina platensis extract improves the production and defenses of the common bean grown in a heavy metals-contaminated saline soil. J. Environ. Sci. 2023, 129, 240–257. [Google Scholar] [CrossRef]
- Papathanasiou, F.; Ninou, E.; Mylonas, I.; Baxevanos, D.; Papadopoulou, F.; Avdikos, I.; Sistanis, I.; Koskosidis, A.; Vlachostergios, D.N.; Stefanou, S.; et al. The Evaluation of Common Bean (Phaseolus vulgaris L.) Genotypes under Water Stress Based on Physiological and Agronomic Parameters. Plants 2022, 11, 2432. [Google Scholar] [CrossRef]
- Zhang, Q.; Geng, J.; Du, Y.; Zhao, Q.; Zhang, W.; Fang, Q.; Yin, Z.; Li, J.; Yuan, X.; Fan, Y.; et al. Heat shock transcription factor (Hsf) gene family in common bean (Phaseolus vulgaris): Genome-wide identification, phylogeny, evolutionary expansion and expression analyses at the sprout stage under abiotic stress. BMC Plant Biol. 2022, 22, 33. [Google Scholar] [CrossRef]
- Jin, Y.Z.; Xiong, Y.N.; Xu, C.J.; Ren, J.L.; Guo, Y.X.; Zuo, Y.H.; Zhang, Y.L.; Geng, X.Q. First Report of Alternaria alternata Causing Leaf Spot on Kidney Bean in China. Plant Dis. 2022, 106, 1531. [Google Scholar] [CrossRef]
- Armitage, A.D.; Cockerton, H.M.; Sreenivasaprasad, S.; Woodhall, J.; Lane, C.R.; Harrison, R.J.; Clarkson, J.P. Genomics Evolutionary History and Diagnostics of the Alternaria alternata Species Group Including Apple and Asian Pear Pathotypes. Front. Microbiol. 2020, 10, 3124. [Google Scholar] [CrossRef]
- Shalaby, T.A.; Taha, N.A.; Taher, D.I.; Metwaly, M.M.; El-Beltagi, H.S.; Rezk, A.A.; El-Ganainy, S.M.; Shehata, W.F.; El-Ramady, H.R.; Bayoumi, Y.A. Paclobutrazol Improves the Quality of Tomato Seedlings to Be Resistant to Alternaria solani Blight Disease: Biochemical and Histological Perspectives. Plants 2022, 11, 425. [Google Scholar] [CrossRef] [PubMed]
- Kokaeva, L.Y.; Yarmeeva, M.M.; Kokaeva, Z.G.; Chudinova, E.M.; Balabko, P.N.; Elansky, S.N. Phylogenetic Study of Alternaria Potato and Tomato Pathogens in Russia. Diversity 2022, 14, 685. [Google Scholar] [CrossRef]
- Ertoy, N. Morphological and Molecular Characterization of Alternaria alternata Causing Leaf Spot in Faba Bean (Vicia faba L.) and Determination of The Disease Reactions of Some Faba Bean Varieties Grown in Turkey. Gesunde Pflanz. 2022. [Google Scholar] [CrossRef]
- Budde-Rodriguez, S.; Pasche, J.S.; Mallik, I.; Gudmestad, N.C. Sensitivity of Alternaria spp. from potato to pyrimethanil, cyprodinil, and fludioxonil. J. Crop. Prot. 2022, 152, 105855. [Google Scholar] [CrossRef]
- Tleuova, A.B.; Wielogorska, E.; Prasad Talluri, V.S.S.L.; Štěpánek, F.; Elliott, C.T.; Grigoriev, D.O. Recent advances and remaining barriers to producing novel formulations of fungicides for safe and sustainable agriculture. J. Control. Release 2020, 326, 468–481. [Google Scholar] [CrossRef]
- Simon-Delso, N.; San Martin, G.; Bruneau, E.; Hautier, L. Time-to-death approach to reveal chronic and cumulative toxicity of a fungicide for honeybees not revealed with the standard ten-day test. Sci. Rep. 2018, 8, 7241. [Google Scholar] [CrossRef] [PubMed]
- Quiterio-Gutiérrez, T.; Ortega-Ortiz, H.; Cadenas-Pliego, G.; Hernández-Fuentes, A.; Sandoval-Rangel, A.; Benavides-Mendoza, A.; la Fuente, M.C.; Juárez-Maldonado, A. The Application of Selenium and Copper Nanoparticles Modifies the Biochemical Responses of Tomato Plants under Stress by Alternaria solani. Int. J. Mol. Sci. 2019, 20, 1950. [Google Scholar] [CrossRef]
- Bramhanwade, K.; Shende, S.; Bonde, S.; Gade, A.; Rai, M. Fungicidal activity of Cu nanoparticles against Fusarium causing crop diseases. Environ. Chem. Lett. 2016, 14, 229–235. [Google Scholar] [CrossRef]
- Kutawa, A.B.; Ahmad, K.; Ali, A.; Hussein, M.Z.; Abdul Wahab, M.A.; Adamu, A.; Ismaila, A.A.; Gunasena, M.T.; Rahman, M.Z.; Hossain, M.I. Trends in Nanotechnology and Its Potentialities to Control Plant Pathogenic Fungi: A Review. Biology 2021, 10, 881. [Google Scholar] [CrossRef]
- Sardar, M.; Ahmed, W.; Al Ayoubi, S.; Nisa, S.; Bibi, Y.; Sabir, M.; Khan, M.M.; Ahmed, W.; Qayyum, A. Fungicidal synergistic effect of biogenically synthesized zinc oxide and copper oxide nanoparticles against Alternaria citri causing citrus black rot disease. Saudi J. Biol. Sci. 2022, 29, 88–95. [Google Scholar] [CrossRef] [PubMed]
- Periakaruppan, R.; Palanimuthu, V.; Abed, S.A.; Danaraj, J. New perception about the use of nanofungicides in sustainable agriculture practices. Arch. Microbiol. 2023, 205, 4. [Google Scholar] [CrossRef] [PubMed]
- Cordon, G.; Valiño, I.L.; Prieto, A.; Costa, C.; Marchi, M.C.; Diz, V. Effects of the nanoherbicide made up of atrazine-chitosan on the primary events of photosynthesis. J. Photochem. Photobiol. 2022, 12, 100144. [Google Scholar] [CrossRef]
- Shivashakarappa, K.; Reddy, V.; Tupakula, V.K.; Farnian, A.; Vuppula, A.; Gunnaiah, R. Nanotechnology for the detection of plant pathogens. Plant Nano Biol. 2022, 2, 100018. [Google Scholar] [CrossRef]
- El-Gazzar, N.; Ismail, A.M. The potential use of Titanium, Silver and Selenium nanoparticles in controlling leaf blight of tomato caused by Alternaria alternata. Biocatal. Agric. Biotechnol. 2020, 27, 101708. [Google Scholar] [CrossRef]
- Perez-Zavala, F.G.; Atriztan-Hernandez, K.; Mart´ınez-Irastorza, P.; Oropeza-Aburto, A.; Lopez-Arredondo, D.; Herrera-Estrella, L. Titanium nanoparticles activate a transcriptional response in Arabidopsis that enhances tolerance to low phosphate, osmotic stress and pathogen infection. Front. Plant Sci. 2022, 13, 994523. [Google Scholar] [CrossRef]
- Paul, A.; Roychoudhury, A. Go green to protect plants: Repurposing the antimicrobial activity of biosynthesized silver nanoparticles to combat phytopathogens. Nanotechnol. Environ. Eng. 2021, 6, 10. [Google Scholar] [CrossRef]
- Wang, Z.L.; Zhang, X.; Fan, G.J.; Que, Y.; Xue, F.; Liu, Y.H. Toxicity Effects and Mechanisms of MgO Nanoparticles on the Oomycete Pathogen Phytophthora infestans and Its Host Solanum tuberosum. Toxics 2022, 10, 553. [Google Scholar] [CrossRef]
- Parveen, A.; Siddiqui, Z.A. Impact of silicon dioxide nanoparticles on growth, photosynthetic pigments, proline, activities of defense enzymes and some bacterial and fungal pathogens of tomato. Vegetos 2022, 35, 83–93. [Google Scholar] [CrossRef]
- Kamel, S.M.; Elgobashy, S.F.; Omara, R.I.; Derbalah, A.S.; Abdelfatah, M.; El-Shaer, A.; Al-Askar, A.A.; Abdelkhalek, A.; Abd-Elsalam, K.A.; Essa, T.; et al. Antifungal Activity of Copper Oxide Nanoparticles against Root Rot Disease in Cucumber. J. Fungi 2022, 8, 911. [Google Scholar] [CrossRef]
- Khan, M.R.; Siddiqui, Z.A. Use of silicon dioxide nanoparticles for the management of Meloidogyne incognita, Pectobacterium betavasculorum and Rhizoctonia solani disease complex of beetroot (Beta vulgaris L.). Sci. Hortic. 2020, 265, 109211. [Google Scholar] [CrossRef]
- Riseh, R.S.; Hassanisaadi, M.; Vatankhah, M.; Soroush, F.; Varma, R.S. Nano/microencapsulation of plant biocontrol agents by chitosan, alginate, and other important biopolymers as a novel strategy for alleviating plant biotic stresses. Int. J. Biol. Macromol. 2022, 222 Pt A, 1589–1604. [Google Scholar] [CrossRef]
- El-Ramady, H.; Alshaal, T.; Elhawat, N.; El-Nahrawy, E.; Omara, A.E.-D.; El-Nahrawy, S.; Elsakhawy, T.; Ghazi, A.; Abdalla, N.; Fári, M. Biological aspects of selenium and silicon nanoparticles in the terrestrial environments. In Phytoremediation: Management of Environmental Contaminants; Ansari, A.A., Gill, S.S., Gill, R., Lanza, G., Newman, L., Eds.; Springer International Publishing: Cham, Switzerland, 2018; pp. 235–264. [Google Scholar]
- Zahedi, S.M.; Moharrami, F.; Sarikhani, S.; Padervand, M. Selenium and silica nanostructure-based recovery of strawberry plants subjected to drought stress. Sci. Rep. 2020, 10, 17672. [Google Scholar] [CrossRef] [PubMed]
- Hussain, B.; Lin, Q.; Hamid, Y.; Sanaullah, M.; Di, L.; Hashmi, M.L.R.; Khan, M.B.; He, Z.; Yang, X. Foliage application of selenium and silicon nanoparticles alleviates Cd and Pb toxicity in rice (Oryza sativa L.). Sci. Total Environ. 2020, 712, 136497. [Google Scholar] [CrossRef] [PubMed]
- Badawy, S.A.; Zayed, B.A.; Bassiouni, S.M.A.; Mahdi, A.H.A.; Majrashi, A.; Ali, E.F.; Seleiman, M.F. Influence of Nano Silicon and Nano Selenium on Root Characters, Growth, Ion Selectivity, Yield, and Yield Components of Rice (Oryza sativa L.) under Salinity Conditions. Plants 2021, 10, 1657. [Google Scholar] [CrossRef] [PubMed]
- El-Saadony, M.T.; Desoky, E.M.; Saad, A.M.; Rania, S.M.; Eid, R.S.M.; Selem, S.; Elrys, A.S. Biological silicon nanoparticles improve Phaseolus vulgaris L. yield and minimize its contaminant contents on a heavy metals-contaminated saline soil. J. Environ. Sci. 2021, 106, 1–14. [Google Scholar] [CrossRef]
- Joshi, S.M.; De Britto, S.; Jogaiah, S. Myco-engineered selenium nanoparticles elicit resistance against tomato late blight disease by regulating differential expression of cellular, biochemical and defense responsive genes. J. Biotechnol. 2021, 325, 196–206. [Google Scholar] [CrossRef] [PubMed]
- Bhat, K.A.; Batool, A.; Mansoor, M.; Manzoor, M.; Bashir, Z.; Nazir, M.; Zargar, S.M. Silicon- and nanosilicon-mediated disease resistance in crop plants. In Silicon and Nano-silicon in Environmental Stress Management and Crop Quality Improvement; Etesami, H., Al Saeedi, A.H., El-Ramady, H., Fujita, M., Pessarakli, M., Hossain, M.A., Eds.; Academic Press: Cambridge, MA, USA, 2022; pp. 193–205. [Google Scholar]
- Dhakate, P.; Kandhol, N.; Raturi, G.; Ray, P.; Bhardwaj, A.; Srivastava, A.; Kaushal, L.; Singh, A.; Pandey, S.; Sharma, S.; et al. Silicon nanoforms in crop improvement and stress management. Chemosphere 2022, 305, 135165. [Google Scholar] [CrossRef]
- El-Ramady, H.; Abdalla, N.; El-Mahrouk, M.E.; Bayoumi, Y.; Elsakhawy, T.; Omara, A.E.-D.; Shalaby, T.A. Anatomical Changes of Cultivated Plants under Combined Stress: An Urgent Need for Investigation. Environ. Biodivers. Soil Secur. 2021, 5, 73–83. [Google Scholar] [CrossRef]
- Panwar, V.; Gangwar, R.K.; Javeria, S.; Yadav, R.S. Antifungal efficacy of fungicides and bio-control agents against leaf spot pathogens, Alternaria alternata. Curr. Discov. 2013, 2, 128–133. [Google Scholar]
- Ozcelik, N.S.; Ozcelik, S. Investigation on some factors and strains affecting the production of Alternaria-toxins by a thin layer chromatographic method. Turk. J. Agric. For. 1997, 21, 1–5. [Google Scholar] [CrossRef]
- Ghazi, A.A.; El-Nahrawy, S.; El-Ramady, H.; Ling, W. Biosynthesis of Nano-Selenium and Its Impact on Germination of Wheat under Salt Stress for Sustainable Production. Sustainability 2022, 14, 1784. [Google Scholar] [CrossRef]
- Ferreira, J.H.; Mathee, F.N.; Thomas, A.C. Biological control of Eutypalota on grapevine by an antagonistic strain of Bacillus subtilis. Phytopathology 1991, 81, 283–287. [Google Scholar] [CrossRef]
- Pandy, H.N.; Menon, T.C.M.; Rao, M.V. Simple formula for calculating area under disease progress curve. Rachis 1989, 8, 38–39. [Google Scholar]
- Nagata, M.; Yamashita, I. Simple Method for Simultaneous Determinations of Chlorophyll and Carotenoids in Tomato Fruit. Nippon. Shokuhin Kogyo Gakkaishi 1992, 39, 925–928. [Google Scholar] [CrossRef]
- Maxwell, K.; Johnson, G.N. Chlorophyll Fluorescence—A Practical Guide. J. Exp. Bot. 2000, 51, 659–668. [Google Scholar] [CrossRef] [PubMed]
- Aebi, H. Catalase in Vitro. In Methods in Enzymology; Packer, L., Ed.; Academic Press: San Diego, CA, USA, 1984; pp. 121–126. [Google Scholar]
- Rathmell, W.G.; Sequeira, L. Soluble Peroxidase in Fluid from the Intercellular Spaces of Tobacco Leaves. Plant Physiol. 1974, 53, 317–318. [Google Scholar] [CrossRef]
- Malik, C.P.; Singh, M.B. Plant Emynology and Histo-Enzymology; Kalyani Publishers: New Delhi, India, 1980. [Google Scholar]
- Binsan, W.; Benjakul, S.; Visessanguan, W.; Roytrakul, S.; Tanaka, M.; Kishimura, K. Antioxidative activity of Mungoong, an extract paste, from the cephalothorax of white shrimp (Litopenaeus vannamei). Food Chem. 2008, 106, 185–193. [Google Scholar] [CrossRef]
- Whitlow, T.H.; Bassuk, N.L.; Ranney, T.G.; Reichert, D.L. An improved method for using electrolyte leakage to assess membrane competence in plant tissues. Plant Physiol. 1992, 98, 198–205. [Google Scholar] [CrossRef]
- Szalai, G.; Janda, T.; Paldi, E.; Szigeti, Z. Role of light in the development of post- chilling symptoms in maize. J. Plant Physiol. 1996, 148, 378–383. [Google Scholar] [CrossRef]
- Snedecor, G.W.; Cochran, W.G. Statistical Methods, 8th ed.; Iowa State University Press: Ames, IA, USA, 1989. [Google Scholar]
- Yu, S.; Zhen, C.; Zhao, P.; Li, J.; Qin, Z.; Gao, H. Antifungal mechanisms of γ-aminobutyric acid against the postharvest pathogen Alternaria alternata. LWT 2023, 173, 114314. [Google Scholar] [CrossRef]
- Ghooshkhaneh, N.G.; Golzarian, M.R.; Mollazade, K. VIS-NIR spectroscopy for detection of citrus core rot caused by Alternaria alternata. Food Control. 2023, 144, 109320. [Google Scholar] [CrossRef]
- Kotzybik, K.; Graf, V.; Kugler, L.; Stoll, D.A.; Greiner, R.; Geisen, R.; Schmidt-Heydt, M. Influence of different nanomaterials on growth and mycotoxin production of Penicillium verrucosum. PLoS ONE 2016, 11, e0150855. [Google Scholar] [CrossRef] [PubMed]
- Vera-Reyes, I.; Altamirano-Hernández, J.; Reyes-de la Cruz, H.; Granados-Echegoyen, C.A.; Loera-Alvarado, G.; López-López, A.; Garcia-Cerda, L.A.; Loera-Alvarado, E. Inhibition of phytopathogenic and beneficial fungi applying silver nanoparticles in vitro. Molecules 2022, 27, 8147. [Google Scholar] [CrossRef] [PubMed]
- Yang, Z.X.; Yang, Y.F.; Yu, S.Z.; Wang, R.G.; Wang, Y.; Chen, H.L. Photosynthetic, photochemical and osmotic regulation changes in tobacco resistant and susceptible to Alternaria alternata. Trop. Plant Pathol. 2018, 43, 413–421. [Google Scholar] [CrossRef]
- Tripathi, D.; Singh, M.; Pandey-Rai, S. Crosstalk of nanoparticles and phytohormones regulate plant growth and metabolism under abiotic and biotic stress. Plant Stress 2022, 6, 100107. [Google Scholar] [CrossRef]
- El-Badri, A.M.; Ahmed, M.; Hashem, A.M.; Batool, M.; Ahmed Sherif, A.; Nishawy, E.; Ayaad, M.; Hassan, H.M.; Elrewainy, I.M.; Wang, J.; et al. Comparative efficacy of bio-selenium nanoparticles and sodium selenite on morpho-physiochemical attributes under normal and salt stress conditions, besides selenium detoxification pathways in Brassica napus L. J. Nanobiotechnol. 2022, 20, 163. [Google Scholar] [CrossRef]
- Wang, L.; Ning, C.; Pan, T.; Cai, K. Role of Silica Nanoparticles in Abiotic and Biotic Stress Tolerance in Plants: A Review. Int. J. Mol. Sci. 2022, 23, 1947. [Google Scholar] [CrossRef]
- Shalaby, T.A.; Abd-Alkarim, E.; El-Aidy, F.; Hamed, E.; Sharaf-Eldin, M.; Taha, N.; El-Ramady, H.; Bayoumi, Y.; dos Reis, A.R. Nano-selenium, silicon and H2O2 boost growth and productivity of cucumber under combined salinity and heat stress. Ecotoxicol. Environ. Saf. 2021, 212, 111962. [Google Scholar] [CrossRef]
- El-Saadony, M.T.; Saad, A.M.; Najjar, A.A.; Alzahrani, S.O.; Alkhatib, F.M.; Shafi, M.E.; Selem, E.; Desoky, E.S.M.; Fouda, S.E.; El-Tahan, A.M.; et al. The use of biological selenium nanoparticles to suppress Triticum aestivum L. crown and root rot diseases induced by Fusarium species and improve yield under drought and heat stress. Saudi J. Biol. Sci. 2021, 28, 4461–4471. [Google Scholar] [CrossRef]
- Zhu, Y.; Dong, Y.; Zhu, N.; Jin, H. Foliar application of biosynthetic nano-selenium alleviates the toxicity of Cd, Pb, and Hg in Brassica chinensis by inhibiting heavy metal adsorption and improving antioxidant system in plant. Ecotoxicol. Environ. Saf. 2022, 240, 113681. [Google Scholar] [CrossRef] [PubMed]
- El-Badri, A.M.; Batool, M.; Mohamed, I.A.A.; Wang, Z.; Wang, C.; Tabl, K.M.; Khatab, A.; Kuai, J.; Wang, J.; Wang, B.; et al. Mitigation of the salinity stress in rapeseed (Brassica napus L.) productivity by exogenous applications of bio-selenium nanoparticles during the early seedling stage. Environ. Pollut. 2022, 310, 119815. [Google Scholar] [CrossRef] [PubMed]
- Albalawi, M.A.; Abdelaziz, A.M.; Attia, M.S.; Saied, E.; Elganzory, H.H.; Hashem, A.H. Mycosynthesis of Silica Nanoparticles Using Aspergillus niger: Control of Alternaria solani Causing Early Blight Disease, Induction of Innate Immunity and Reducing of Oxidative Stress in Eggplant. Antioxidants 2022, 11, 2323. [Google Scholar] [CrossRef] [PubMed]
- Kapoor, B.; Kumar, P.; Gill, N.S.; Sharma, R.; Thakur, N.; Irfan, M. Molecular mechanisms underpinning the silicon-selenium (Si-Se) interactome and cross-talk in stress-induced plant responses. Plant Soil 2022. [Google Scholar] [CrossRef]
- Saffan, M.M.; Koriem, M.A.; El-Henawy, A.; El-Mahdy, S.; El-Ramady, H.; Elbehiry, F.; Omara, A.E.-D.; Bayoumi, Y.; Badgar, K.; Prokisch, J. Sustainable Production of Tomato Plants (Solanum lycopersicum L.) under Low-Quality Irrigation Water as Affected by Bio-Nanofertilizers of Selenium and Copper. Sustainability 2022, 14, 3236. [Google Scholar] [CrossRef]

| Code | Description of the Treatment (s) |
|---|---|
| T1 | Untreated plants |
| T2 | Foliar application of 100 ppm biologically synthesized nano-Se from Agricultural Microbiology Research Department (Giza, Egypt) |
| T3 | Foliar application of 200 ppm fine-ground nano-Si from Agricultural Microbiology Research Department (Giza, Egypt) |
| T4 | Foliar application of 50% of T2 and T3 (i.e., 50 ppm of nano-Se + 100 ppm of nano-SiO2) |
| T5 | Spraying of commercial fungicide Score 250 EC (Difenoconazole, dose 1 mL/2 L from Syngenta (Basel, Switzerland) |
| Isolate No. | Disease Severity (%) |
|---|---|
| A1 | 41.30 b ± 2.05 |
| A2 | 23.00 c ± 1.99 |
| A3 | 27.15 c ± 2.00 |
| A4 | 14.37 d ± 1.89 |
| A5 | 78.23 a ± 3.47 |
| A6 | 30.00 c ± 2.08 |
| F. test | ** |
| Treatments | Mycelial Growth (cm) | Reduction (%) |
|---|---|---|
| Negative control | 9.0 a ± 0.21 | 0.001 f ± 0.00 |
| Nano-Se (25 ppm) | 7.0 b ± 0.17 | 22.22 e ± 0.95 |
| Nano-Se (50 ppm) | 4.5 c ± 0. 08 | 50.00 cd ± 2.47 |
| Nano-Se (100 ppm) | 1.7 d ± 0. 08 | 85.11 b ± 3. 11 |
| Nano-Si (100 ppm) | 6.0 b ± 0. 15 | 33.33 e ± 2.09 |
| Nano-Si (200 ppm) | 3.5 c ± 0. 11 | 61.11 c ± 3.01 |
| 1/2 Nano-(Se + Si) (i.e., 50 + 100 ppm, respectively) | 2.0 d ± 0. 05 | 77.78 bc ± 3.34 |
| Fungicide (Score 250 EC) | 0.4 e ± 0. 01 | 95.55 a ± 4. 37 |
| F. test | ** | ** |
| Treatments | Disease Severity (%) | Efficacy (%) | |||
|---|---|---|---|---|---|
| Days after Sowing Date | |||||
| 45 | 60 | 75 | 90 | ||
| Season of 2021 | |||||
| T1 | 29.5 a ± 1.24 | 42.1 a ± 2.56 | 61.8 a ± 3.18 | 89.6 a ± 3.76 | ------- |
| T2 | 1.5 b ± 0.16 | 5.5 b ± 0.48 | 14.8 c ± 0.53 | 20.5 c ± 1.08 | 77.1 ab ± 2.55 |
| T3 | 3.3 b ± 0.23 | 7.5 b ± 0.59 | 18.1 b ± 0.73 | 30.3 b ± 1.22 | 66.1 c ± 2.29 |
| T4 | 0.0 b ± 0.00 | 5.8 b ± 0.49 | 15.1 c ± 0.48 | 23.5 bc ± 1.18 | 73.7 b ± 2.51 |
| T5 | 0.0 b ± 0.00 | 6.2 b ± 0.61 | 12.5 d ± 0.67 | 17.8 c ± 0.79 | 80.1 a ± 3.05 |
| F. test | ** | ** | ** | ** | ** |
| Season of 2022 | |||||
| T1 | 31.3 a ± 3.04 | 49.1 a ± 4.49 | 66.0 a ± 4.99 | 94.6 a ± 4.99 | -------- |
| T2 | 2.4 c ± 0.10 | 10.4 b ± 0.47 | 17.0 cd ± 1.02 | 23.0 c ± 1.06 | 75.7 a ± 4.04 |
| T3 | 6.0 b ± 0.17 | 13.0 b ± 0.47 | 22.1 b ± 1.06 | 35.0 b ± 2.08 | 63.0 c ± 3.95 |
| T4 | 3.5 c ± 0.14 | 11.7 b ± 0.47 | 19.1 c ± 1.06 | 27.8 b ± 2.05 | 70.5 b ± 4.04 |
| T5 | 1.9 c ± 0.07 | 8.3 c ± 0.35 | 14.7 d ± 1.02 | 20.9 c ± 1.79 | 77.9 a ± 4.04 |
| F. test | ** | ** | ** | ** | * |
| Treatments | Stem Length (cm) | No. of Leaves/Plant | Plant Fresh Mass (g) | Plant Dry Mass (g) | Chlorophyll Fluorescence (FV/FM) | Chl. A | Chl. B |
|---|---|---|---|---|---|---|---|
| (mg 100 g−1 FW) | |||||||
| Season of 2021 | |||||||
| T1 | 43.7 c | 14.2 d | 60.5 d | 13.66 d | 0.724 c | 18.22 c | 8.14 b |
| T2 | 54.0 a | 19.1 a | 101.5 a | 22.14 a | 0.798 a | 23.99 a | 9.23 a |
| T3 | 51.6 b | 17.3 b | 93.6 b | 19.55 b | 0.795 a | 22.17 b | 8.36 b |
| T4 | 53.3 a | 17.5 b | 95.2 b | 20.05 b | 0.795 a | 23.05 ab | 8.55 b |
| T5 | 50.6 b | 15.7 c | 84.6 c | 17.99 c | 0.771 b | 23.99 a | 9.18 a |
| F-test | ** | ** | ** | ** | ** | ** | * |
| Season of 2022 | |||||||
| T1 | 40.4 c | 11.8 c | 57.1 d | 12.45 d | 0.733 c | 17.09 c | 8.02 a |
| T2 | 51.8 a | 16.7 a | 94.7 a | 19.77 a | 0.778 a | 22.55 a | 9.02 a |
| T3 | 48.9 b | 14.7 b | 86.3 b | 17.56 b | 0.776 a | 20.08 b | 8.34 a |
| T4 | 50.1 ab | 15.5 ab | 85.7 b | 17.89 b | 0.777 a | 20.60 b | 8.45 a |
| T5 | 48.5 b | 14.5 b | 79.4 c | 16.05 c | 0.754 b | 21.95 a | 8.88 a |
| F-test | * | * | ** | ** | * | ** | NS |
| Treatments | Dry Seed Yield (g plant−1) | Dry Seed Yield (Mg ha−1) | Dry Seed Yield (g plant−1) | Dry Seed Yield (Mg ha−1) |
|---|---|---|---|---|
| Season of 2021 | Season of 2022 | |||
| T1 | 30.85 d ± 2.05 | 2.17 c ± 0.009 | 27.19 d ± 3.03 | 1.77 e ± 0.019 |
| T2 | 54.22 a ± 2.79 | 3.07 a ± 0.017 | 45.75 a± 3.55 | 2.66 a ± 0.025 |
| T3 | 38.99 c ± 2.48 | 2.48 b ± 0.025 | 32.27 c ± 3.35 | 2.24 d ± 0.033 |
| T4 | 49.13 ab ± 2.75 | 2.77 a ± 0.032 | 40.18 b ± 3.44 | 2.49 b ± 0.029 |
| T5 | 45.88 b ± 2.57 | 2.61 b ± 0.044 | 38.65 b ± 4.01 | 2.41 c ± 0.018 |
| F-test | ** | ** | ** | ** |
Disclaimer/Publisher’s Note: The statements, opinions and data contained in all publications are solely those of the individual author(s) and contributor(s) and not of MDPI and/or the editor(s). MDPI and/or the editor(s) disclaim responsibility for any injury to people or property resulting from any ideas, methods, instructions or products referred to in the content. |
© 2023 by the authors. Licensee MDPI, Basel, Switzerland. This article is an open access article distributed under the terms and conditions of the Creative Commons Attribution (CC BY) license (https://creativecommons.org/licenses/by/4.0/).
Share and Cite
Taha, N.A.; Hamden, S.; Bayoumi, Y.A.; Elsakhawy, T.; El-Ramady, H.; Solberg, S.Ø. Nanofungicides with Selenium and Silicon Can Boost the Growth and Yield of Common Bean (Phaseolus vulgaris L.) and Control Alternaria Leaf Spot Disease. Microorganisms 2023, 11, 728. https://doi.org/10.3390/microorganisms11030728
Taha NA, Hamden S, Bayoumi YA, Elsakhawy T, El-Ramady H, Solberg SØ. Nanofungicides with Selenium and Silicon Can Boost the Growth and Yield of Common Bean (Phaseolus vulgaris L.) and Control Alternaria Leaf Spot Disease. Microorganisms. 2023; 11(3):728. https://doi.org/10.3390/microorganisms11030728
Chicago/Turabian StyleTaha, Naglaa A., Salem Hamden, Yousry A. Bayoumi, Tamer Elsakhawy, Hassan El-Ramady, and Svein Ø. Solberg. 2023. "Nanofungicides with Selenium and Silicon Can Boost the Growth and Yield of Common Bean (Phaseolus vulgaris L.) and Control Alternaria Leaf Spot Disease" Microorganisms 11, no. 3: 728. https://doi.org/10.3390/microorganisms11030728
APA StyleTaha, N. A., Hamden, S., Bayoumi, Y. A., Elsakhawy, T., El-Ramady, H., & Solberg, S. Ø. (2023). Nanofungicides with Selenium and Silicon Can Boost the Growth and Yield of Common Bean (Phaseolus vulgaris L.) and Control Alternaria Leaf Spot Disease. Microorganisms, 11(3), 728. https://doi.org/10.3390/microorganisms11030728

